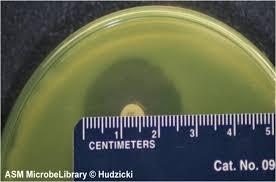
I have attached a file 3

I have attached a file
2420-Lab 8- Control of Microbes: Susceptibility to Antimicrobials
Directions:Answer questions after reading the information and watching the video from the links below. Use color RED for your answers. Submit the completed document on eCampus for grading. Refer to
the textbook Openstax Microbiology Chapter 13
Link: Control of Microbes- I (13-A, B,) (Virtual Edge Experiment-13- A, B)
This document has 25 questions to answer
Students MUST use scientific terminology while answering all questions
For each wrong answer 0.5 points will be deducted
- Lethal Effects of UV radiation:
Read the information from textbook from chapters 5 and 8 review sections 5.4 and 8.3 to answer the following questions.
Watch the following video: 13- A, B, C
What range of wavelength in “nm” is considered ultra-violet radiation?

What is the correlation of energy and wavelength in the electromagnetic spectrum showed above?
Would you consider mutations occurring after exposure to UV light spontaneous or induced?
What are the effects of UV light exposure on DNA?
Can the damage caused by UV light repaired? How?
In the experiment 13-A, why is the cover of petri-dish removed when exposing the bacteria to UV?
What will happen if the person doing experiments with UV light does not protect eyes while actively using UV light?
- Kirby-Bauer Disc Diffusion Method
Read the information from textbook from chapter 20 review section 20.2, 20.4 to answer the following questions.
For background: 13-BDefine the following terms
Bacteriostatic
Bactericidal
Antimicrobial
Antibiotic
Susceptibility
Zone of Inhibition
Selective Toxicity
Therapeutic index
Broad-spectrum antibiotic
Narrow-spectrum antibiotic
Dysbiosis
Kirby-Bauer disc diffusion test procedure:

Finding out susceptibility: by measuring the diameter of the zone of inhibition
What information would you get after performing the Kirby-Bauer experiment?
Why is the zone of inhibition circular?
If the disc used was a square or a triangle, what shape would be the zone of inhibition?
Which antibiotic is the most effective, least effective and not effective against E.coli based on the following picture of the results of a Kirby-Bauer disc diffusion test?

Pfizer, a pharmaceutical company chemically synthesized an antibiotic, Granegin, against E. coli. Observe the initial results of this novel antibiotic in the table below and answer questions 23-25:
At what concentration the novel antibiotic is the most effective against E. coli?
At what concentration the novel antibiotic is the least effective against E. coli?
If you were a health professional, which of the above antibiotic concentrations would you choose for treatment against E. coli infections and why?